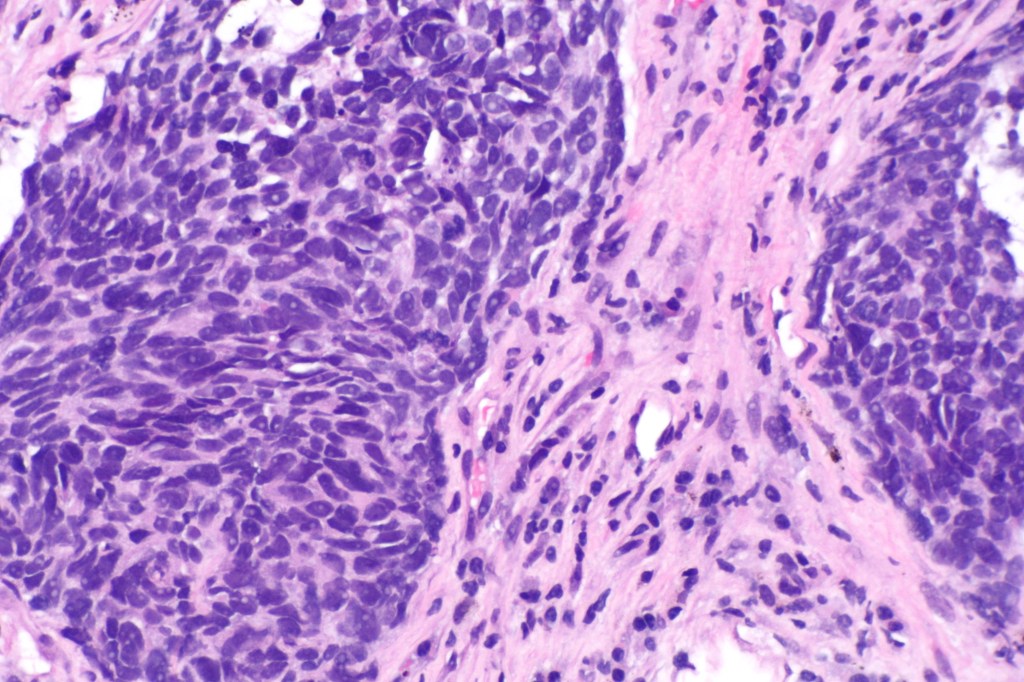

Gaurav Sharma ’22
For the past couple of years, lung cancer has been responsible for the most cancer-related deaths in the general population. One variation of lung cancer is non-small cell lung cancer (NSCLC) which constitutes more than 80% of tumor growths originating in the lungs. NSCLC can be treated but 40% of patients have a recurrence of NSCLC highlighting the critical need for a better prognosis. Epigenetic analysis of lung cancer has been a recent area of interest among cancer researchers since DNA methylation has been associated with the development and progression of cancer. This gave researchers the idea to look more into DNA methylation patterns specifically for NSCLC and see if there are any patterns that could show a stratification of the severity and recurrence of NSCLC among patients.
Researchers first compiled all cases of NSCLC with epigenetic, genomic, and clinical data that was available on The Cancer Genome Atlas. The cases were then screened so that only those with a follow-up time greater than 30 days were considered. Screening narrowed the data set down to 349 samples and more than 200,000 unique methylation sites. Hierarchical clustering and statistical analysis was then applied to the cases and methylation sites. Analysis found that there were 4000 sites where methylation actually influenced the prognosis of NSCLC. Although there were 4000 sites that influenced methylation patterns, the methylation patterns can actually be grouped into 6 molecular subtypes which had varying clinical characteristics and survival. Researchers were also able to generate a RiskScore Model which can be used to show likeliness of survival as well as post-surgical outcomes.
These findings show a novel method for finding the prognosis of NSCLC. The indexes and RiskScore created can be used to help treat patients more effectively and earlier. More work needs to be done to find a better correlation to recurrence of NSCLC and the reliability of the prognosis markers in a clinical setting, but these findings are a step in the right direction. Researchers hope to find more prognostic markers that can help complete the whole picture of the development and progression of NSCLC.
[1] Y. Wang et al. Identification of prognostic signature of non–small cell lung cancer based on TCGA methylation data. Scientific Reports. 10, 8575 (2020). doi: https://doi.org/10.1038/s41598-020-65479-y
[2] Image retrieved from: https://upload.wikimedia.org/wikipedia/commons/9/94/Non-small_cell_lung_carcinoma_–_high_mag.jpg

